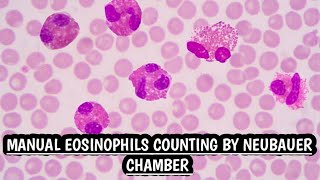

First Pakistani female Medical Laboratory educational Channel ☺️😇
I am a professional medical technologist. My main purpose of making this channel is to help all medical professionals especially lab technicians and technologists through my videos that includes lectures based on important lab topics,practical videos and knowledge about machines and mcqs related to lab subjects to refresh our knowledge & helpful to pass exams for new jobs.
Subscribe my channel so that you will get new videos on time.
i hope mine this effort will help to all of you.
May you all blessed with bright future. be happy and keep other people happy and spread positivity.
thanks to all of you for showing your support.
Shared 2 weeks ago
201 views
Shared 2 weeks ago
350 views
Shared 3 weeks ago
202 views
Shared 4 weeks ago
394 views
Shared 4 weeks ago
285 views
Shared 4 weeks ago
425 views
Shared 4 weeks ago
249 views
Structure and function of Pancreas.Easy & brief explanation in urdu & Hindi#pancreas#knowledge#notes
Shared 1 month ago
135 views
Shared 1 month ago
217 views
Shared 1 month ago
204 views
Shared 1 month ago
183 views
Shared 1 month ago
479 views
Shared 3 months ago
270 views
Shared 3 months ago
317 views
Shared 3 months ago
1.2K views
Shared 3 months ago
530 views
Shared 4 months ago
236 views
Shared 4 months ago
94 views
Shared 4 months ago
235 views
Shared 4 months ago
145 views
Shared 4 months ago
265 views
Shared 4 months ago
254 views
Shared 4 months ago
399 views
Shared 4 months ago
328 views
Shared 4 months ago
191 views
Shared 5 months ago
287 views
Laboratory important safety symbols quiz.Check your level how many symbols you know.Lab symbols quiz
Shared 5 months ago
213 views
Shared 5 months ago
220 views
Shared 5 months ago
294 views
Shared 5 months ago
467 views
Shared 5 months ago
350 views
Shared 5 months ago
376 views
Shared 5 months ago
303 views
Shared 5 months ago
990 views
Shared 5 months ago
315 views
Shared 5 months ago
440 views
Shared 5 months ago
593 views
Shared 6 months ago
373 views
Shared 6 months ago
504 views
Shared 6 months ago
372 views
Needle Stick injury 🩸 protocol.How to prevent from needle prick.Important lab job interview question
Shared 6 months ago
339 views
Troponin I rapid test(Qualitative)method.Cardiac marker test.understand test method & result reading
Shared 6 months ago
432 views
Shared 6 months ago
421 views
Lab technician job interview questions.Moh Oman lab technician job interview questions.Minstry exam.
Shared 7 months ago
1.1K views
Maglumi 2000 machine.Immuology & Hormones analyzer.Brief introduction with all detail.Snibe company.
Shared 7 months ago
2.5K views
Shared 7 months ago
664 views
Shared 7 months ago
501 views
Shared 10 months ago
1.4K views
Shared 11 months ago
779 views
Blood collection technique in laboratory.2 method to collect blood from vein.step by step all detail
Shared 11 months ago
2.5K views
Shared 11 months ago
4K views
Shared 11 months ago
927 views
Shared 1 year ago
2.7K views
Shared 1 year ago
906 views
Shared 1 year ago
1.7K views
Shared 1 year ago
3.1K views
Shared 1 year ago
3.9K views